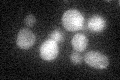
YMR104C
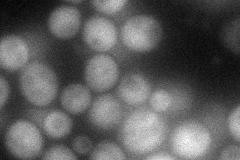
YMR104C
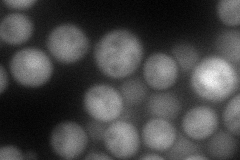
YMR104C
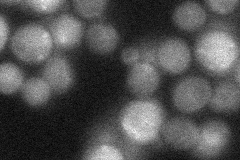
YMR104C
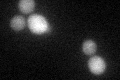
YMR104C

View description
Protein kinase with similarity to serine/threonine protein kinase Ypk1p; functionally redundant with YPK1 at the genetic level; participates in a signaling pathway required for optimal cell wall integrity; homolog of mammalian kinase SGK
Localization:
Intensity:
Fold change:
Significance:
-
C’ GFP library in SD
cytosol23.58 -
N' NOP1pr-GFP in SD
cytosol60.4376 -
N' TEF2pr-mCherry in SD
cytosol81.4621 -
N' NATIVEpr-GFP in SD
cytosol24.8209 -
N' TEF2pr-VC and Cyto-VN in SD

cytosol47.2986 -
C’ GFP library in SD+DTT
cytosol23.951.01No -
C’ GFP library in SD+H2O2

cytosol24.061.02No -
C’ GFP library in Starvation Media

cytosol21.640.91No -
C’ GFP library on the background of Pup2-DaMP

cytosol -
C’ GFP library on the background of CCT mutant

cytosol28.42981.20524No
